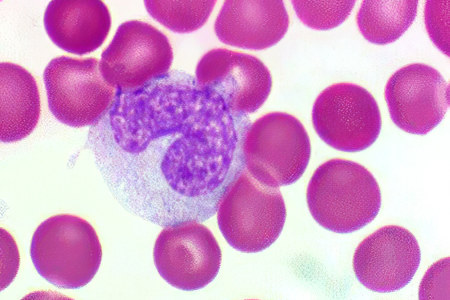
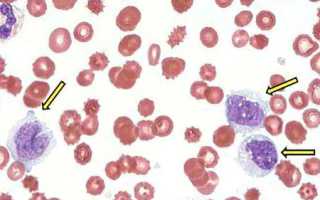

Основные фуникци моноцитов
Моноциты — зрелые одноклеточные лейкоциты, формирующиеся в костном мозге и живущие не более трёх дней. В кровотоке они достигают максимальной активности, продолжают расти и функционировать. Примерно через 70 часов моноциты трансформируются в макрофаги и проникают в окружающие ткани.
Основная задача моноцитов — защита и очищение организма. Перемещаясь по кровеносной системе, они обнаруживают инородные объекты, такие как раковые клетки, инфекции, вирусы и паразиты, и стремятся их уничтожить. Моноциты приближаются к угрозе, обвивают её своим телом, нейтрализуют и выводят из организма. Они также справляются с бактериями, мёртвыми клетками и другими загрязняющими веществами.
Макрофаги действуют по схожему принципу, но для уничтожения вредоносных клеток им требуется больше времени.
Кроме того, моноциты участвуют в синтезе интерферона, что делает клетки менее восприимчивыми к вирусам и усиливает защитные функции организма.
Таким образом, увеличение уровня моноцитов в крови указывает на активную борьбу организма с заболеванием и рост количества защитных клеток.
Повышенные уровни моноцитов могут указывать на различные заболевания и состояния, что вызывает обеспокоенность у врачей. Специалисты отмечают, что моноциты, являясь частью иммунной системы, могут увеличиваться в ответ на инфекции, воспалительные процессы или даже онкологические заболевания. Важно не игнорировать этот симптом и обратиться к врачу для дальнейшего обследования.
Медики рекомендуют провести полный анализ крови и дополнительные исследования, чтобы выявить причину повышения моноцитов. В зависимости от диагноза, лечение может варьироваться от назначения противовоспалительных препаратов до более серьезных мер. Врачи подчеркивают, что игнорирование проблемы может привести к осложнениям, поэтому своевременное обращение за медицинской помощью крайне важно.

Как определяется уровень моноцитов в крови?
Чтобы определить уровень моноцитов в крови, достаточно пройти общий анализ. Моноциты — это один из типов лейкоцитов, и их количество рассчитывается лаборантом с помощью специальной лейкоцитарной формулы. Существует два основных показателя моноцитов:
- Абсолютное количество — обозначается как «моноциты абс» или «моноциты mono» и рассчитывается как среднее число клеток на 1 мкл (микролитр).
- Относительное количество — обозначается как «значение» мнл/л и выражается в процентах.
| Причина повышения моноцитов | Возможные последствия | Что делать |
|---|---|---|
| Инфекционные заболевания (вирусные, бактериальные, паразитарные) | Затяжное течение инфекции, осложнения, развитие сепсиса | Лечение основного заболевания под наблюдением врача, анализ крови для мониторинга |
| Воспалительные процессы (ревматоидный артрит, системная красная волчанка) | Повреждение органов и тканей, хроническая боль, инвалидизация | Лечение основного заболевания, противовоспалительная терапия, симптоматическое лечение |
| Аутоиммунные заболевания | Повреждение собственных тканей организма, развитие органной недостаточности | Иммуносупрессивная терапия, лечение основного заболевания |
| Онкологические заболевания (лейкемия, лимфома) | Развитие анемии, тромбоцитопении, распространение опухоли | Химиотерапия, лучевая терапия, трансплантация костного мозга |
| Гнойные процессы | Сепсис, абсцессы, флегмоны | Хирургическое лечение, антибиотикотерапия |
| Недавно перенесенная операция или травма | Замедленное заживление ран, воспаление | Наблюдение врача, обработка ран, противовоспалительная терапия |
| Некоторые лекарственные препараты | Аллергические реакции, побочные эффекты | Отмена препарата (под контролем врача), симптоматическое лечение |
| Стресс, недосыпание | Снижение иммунитета, ухудшение общего состояния | Нормализация режима дня, снижение стресса, здоровый образ жизни |
Когда необходимо обратиться к врачу и сдать ОАК?
Специфических признаков, указывающих на повышенное количество моноцитов, не существует. Однако моноцитоз может быть связан с другими заболеваниями, симптомы которых косвенно свидетельствуют о изменениях в уровне лейкоцитов.
Рекомендуется обратиться к врачу и сдать анализ в следующих случаях:
- Снижение или полная утрата аппетита.
- Увеличенная утомляемость и необъяснимая слабость.
- Неприязнь к мясным продуктам.
- Резкое снижение веса.
- Проблемы со сном, включая бессонницу и постоянную сонливость.
- Раздражительность, апатия, нервные срывы.
- Повышенная эмоциональная возбудимость.
- Шумная работа желудочно-кишечного тракта.
- Постоянное чувство тревоги.
- Неясные болевые ощущения в области живота.
- Панические атаки.
- Появление пенистых каловых масс.
- Нарушения стула.
- Боли в суставах и мышцах.
- Наличие кровянистых примесей в кале.
- Появление высыпаний на слизистых оболочках.
- Кожные высыпания.
- Долгий сухой кашель с кровянистой мокротой.
- Высыпания и покраснения на половых органах, а также обильные выделения из половых путей.
- Дискомфорт и болезненные ощущения во время полового акта.
Повышенные моноциты в анализе крови могут вызывать беспокойство у многих людей. Часто это состояние указывает на наличие воспалительных процессов в организме, инфекций или даже аутоиммунных заболеваний. Люди делятся своим опытом, отмечая, что важно не паниковать, а обратиться к врачу для дальнейшего обследования. Некоторые рассказывают о том, как изменение рациона питания и образа жизни помогло им нормализовать уровень моноцитов. Например, увеличение потребления антиоксидантов и витаминов может поддержать иммунную систему. Однако не стоит забывать, что только специалист может точно определить причины повышения и назначить соответствующее лечение. Важно следить за своим здоровьем и регулярно проходить медицинские обследования, чтобы предотвратить возможные осложнения.

Отклонения и нормальные значения
В возрасте от рождения до 16 лет нормы моноцитов в крови изменяются. Абсолютные значения, как правило, уменьшаются, в то время как относительные показатели могут колебаться как в сторону понижения, так и повышения до достижения 16 лет.
| Возраст | Нормальные значения MON |
| У новорождённого | 3-12% |
| В первые две недели жизни | Увеличивается до 5-12% |
| К одному году | Снижается до 4-10% |
| К двум годам | Составляет 3-10% |
| С 3 до 16 лет | Нижняя граница остаётся на уровне 3%, верхняя снижается до 1% |
| С 16 лет и до старости | 3-11% |
Абсолютные показатели моноцитов от рождения до 16 лет должны снижаться с 1,9-2,4 млн./л до 0,004-0,08 млн./л.
Состояние, при котором уровень моноцитов в крови ниже нормы, называется моноцитопенией, а при повышении – моноцитозом.
При наличии воспалительного процесса и повышенном уровне моноцитов в анализах можно увидеть обозначение mono. Абсолютный моноцитоз указывает на увеличение общего числа моноцитов.
Изменение процента моноцитов относительно общего количества лейкоцитов называется относительным моноцитозом. Этот показатель может временно увеличиваться по различным причинам, например, после плотного завтрака. Поэтому небольшие отклонения от нормы не имеют значительного диагностического значения.
Однако увеличение количества белых кровяных клеток до 13-17% может указывать на наличие воспалительного процесса, а уровень 18-24% свидетельствует о серьёзном инфекционно-воспалительном состоянии.
Причины повышения моноцитов
Абсолютный моноцитоз у взрослых может возникнуть в следующих ситуациях:
- Хронические заболевания кишечника, такие как болезнь Крона и язвенные колиты.
- Тяжелые хронические недуги, включая ревматоидный и псориатический артрит, а также красную волчанку.
- Отравление веществами, содержащими фосфор, хлор или их соединения.
- Инфекционные заболевания, такие как бруцеллез, сифилис, сальмонеллез, туберкулез, ветрянка, дизентерия, краснуха, грипп и коклюш.
- Ревматологические патологии.
- Ревматизм и эндокардит.
- Заболевания крови, такие как хронический миелолейкоз, остеомиелофиброз, полицитемия, тромбоцитопеническая пурпура и острый лейкоз.
- Сепсис или гнойные процессы.
- Заражение паразитами и вирусами.
- Травмы.
- Злокачественные новообразования лимфатической системы, такие как лимфомы и лимфогранулематоз.
- Инфаркт миокарда.
- Грибковые инфекции.
Повышенное количество моноцитов также может наблюдаться у пациентов в послеоперационный период и в процессе восстановления после инфекций. Недостаток сна, стресс, обильная еда перед анализом и чрезмерные физические нагрузки могут способствовать увеличению уровня моноцитов. Поэтому важно учитывать эти факторы при проведении общего анализа крови.

У мужчин
Не существует особых причин, способствующих повышению уровня моноцитов у мужчин. Моноцитоз может наблюдаться у мужчин, регулярно испытывающих стресс, много работающих и занимающихся деятельностью, связанной с психоэмоциональным напряжением и чрезмерными нервными нагрузками.
У женщин
Увеличенное количество моноцитов у женщин может указывать на инфекции и воспалительные процессы. Нормативные значения лейкоцитов не зависят от пола, однако у женщин уровень моноцитов может повышаться из-за особенностей репродуктивной системы. Например, во время менструации или овуляции это связано с изменениями гормонального фона.
У беременных
Во время беременности и грудного вскармливания уровень лейкоцитов играет критически важную роль для здоровья женщины. Защитные функции организма должны обеспечивать безопасность не только матери, но и развивающегося плода. После рождения ребенка лейкоциты способствуют более быстрому восстановлению сил женщины. В период беременности происходят значительные изменения в иммунной и эндокринной системах, а также колебания гормонального фона, что влияет на соотношение различных типов лейкоцитов.
В первом триместре уровень моноцитов снижается до 1%. Однако через несколько недель этот показатель вновь возрастает до 3%, и такой уровень сохраняется до конца второго триместра. В третьем триместре, в связи с изменениями гормонального фона и подготовкой организма к родам, уровень моноцитов может снова увеличиться. После родов уровень моноцитов снижается, но затем вновь поднимается, что свидетельствует о начале процесса восстановления организма.
У детей
Нормы содержания моноцитов в крови у детей выше, чем у взрослых, причем наивысшие показатели наблюдаются у новорождённых. Не стоит беспокоиться, если возрастные нормы не превышены или отклонение составляет не более 10%. Увеличение уровня моноцитов может указывать на инфекционные или вирусные заболевания, а также на заражение гельминтами. Часто повышение лейкоцитарных показателей связано со сменой молочных зубов на коренные, что связано с формированием новых тканей.
Рост моноцитов также может быть обусловлен наследственными факторами, послеоперационным состоянием или более серьезными заболеваниями, такими как лейкоз. Важно отметить, что у детей чаще наблюдается пониженный уровень лейкоцитов (моноцитопения), что является тревожным признаком и может указывать на истощение организма и его низкую устойчивость к негативным воздействиям.
Чем опасно повышение моноцитов?
Повышение уровня моноцитов в организме чаще всего указывает на наличие заболевания. При инфекции организм активизирует защитные механизмы, увеличивая выработку белых кровяных клеток для борьбы с недугом. На первый взгляд, увеличение количества моноцитов может показаться положительным, так как это способствует более эффективной защите. Однако избыток моноцитов может привести к воспалительным процессам.
Скопления белых клеток в кровеносных сосудах могут:
- Привести к нарушению кровообращения.
- Усугубить атеросклероз.
- Снизить приток крови к сердечной мышце.
- Вызвать повреждение стенок сосудов.
Как снизить уровень моноцитов?
Даже незначительное увеличение уровня моноцитов требует внимания. Такие изменения могут указывать на воспалительный процесс в организме. Чем раньше пациент обратится к врачу, тем быстрее и легче можно будет справиться с лейкоцитозом. Однако многие не знают, к какому специалисту обратиться, так как повышенные моноциты могут быть связаны с различными заболеваниями.
- Первым шагом стоит посетить терапевта. Этот врач соберет анамнез, при необходимости назначит дополнительные анализы и направит к нужному специалисту.
- Если у пациента грипп или ОРВИ, терапевт займется лечением, назначив курс витаминов, антибиотиков и других симптоматических препаратов.
- При выявлении гельминтоза (например, аскаридоз) терапевт назначит специальный курс противопаразитарных таблеток. При тяжелой гельминтизации (например, бычий цепень) потребуется помощь гастроэнтеролога и инфекциониста.
- Инфекционист также необходим при диагностике таких заболеваний, как ветрянка, дизентерия, корь и других. В таких случаях пациента госпитализируют и назначают необходимое лечение.
- Если терапевт обнаружил обострение заболеваний ЖКТ (язва, гастрит, энтерит и т.д.), лечением займется гастроэнтеролог. Основная задача – достичь ремиссии, для чего пациенту назначаются аминосалицилаты, иммуномодуляторы и кортикостероиды. После завершения курса пациент сдает контрольный анализ, и нормальный уровень лейкоцитов будет свидетельствовать о наступлении ремиссии.
- При сифилисе лечение проводится в кожно-венерологическом диспансере, где назначаются общеукрепляющие препараты и курс антибиотиков.
- Злокачественные образования — одни из самых серьезных заболеваний, и их лечением занимается онколог. Врач проводит обследование, определяет стадию заболевания, степень распространения и локализацию опухоли. В зависимости от этих факторов назначается курс лучевой терапии, химиотерапии или оперативное вмешательство. Для каждого пациента разрабатывается индивидуальный план лечения, но цель остается неизменной — предотвратить распространение опухоли.
- Если увеличение моноцитов связано со стрессом, помощь может оказать психолог, а в более сложных случаях — психотерапевт. В лечении используются средства для контроля психоэмоционального состояния, а также психотерапевтические сеансы.
Важно отметить, что независимо от причины повышения моноцитов, в комплекс лечения обязательно должно входить правильное питание. Рекомендуется исключить алкоголь и сахар, а также добавить в рацион морепродукты и рыбу, богатую омега-кислотами. Необходимо увеличить потребление фруктов, овощей, цельнозерновых продуктов и орехов, что поможет нормализовать уровень лейкоцитов.
Вопрос-ответ
Чем опасно повышение моноцитов в крови?
Высокое количество моноцитов является признаком хронического воспаления или того, что организм ведет борьбу с бактериальными, грибковыми или паразитарными инфекциями. Свидетельствует о восстановлении после перенесенного заболевания.
Как привести в норму моноциты?
Чтобы привести в норму уровень моноцитов, необходимо выявить и устранить основную причину их повышения или пониженного уровня. Это может включать лечение инфекций, воспалительных заболеваний, анемии или других медицинских состояний. Также важно поддерживать здоровый образ жизни: правильно питаться, заниматься физической активностью, избегать стресса и соблюдать режим сна. В случае необходимости рекомендуется обратиться к врачу для проведения дополнительных исследований и назначения соответствующего лечения.
Что такое моноциты простыми словами?
Моноциты — разновидность лейкоцитов (белых кровяных телец), которые уничтожают вирусы, бактерии, грибки и другие патогены, угрожающие здоровью. Моноциты больше по размеру, чем остальные виды лейкоцитов, а их мембрана способна формировать выросты.
Советы
СОВЕТ №1
Обратитесь к врачу для диагностики. Повышенные уровни моноцитов могут указывать на различные заболевания, поэтому важно пройти полное медицинское обследование, чтобы выявить причину и получить соответствующее лечение.
СОВЕТ №2
Следите за своим питанием. Убедитесь, что ваш рацион богат витаминами и минералами, особенно витаминами группы B и C, которые поддерживают иммунную систему и могут помочь в нормализации уровня моноцитов.
СОВЕТ №3
Управляйте стрессом. Хронический стресс может влиять на уровень моноцитов, поэтому практикуйте методы релаксации, такие как медитация, йога или прогулки на свежем воздухе, чтобы снизить уровень стресса и улучшить общее состояние здоровья.
СОВЕТ №4
Регулярно проходите медицинские обследования. Это поможет вам отслеживать уровень моноцитов и другие показатели здоровья, а также вовремя реагировать на изменения в организме.